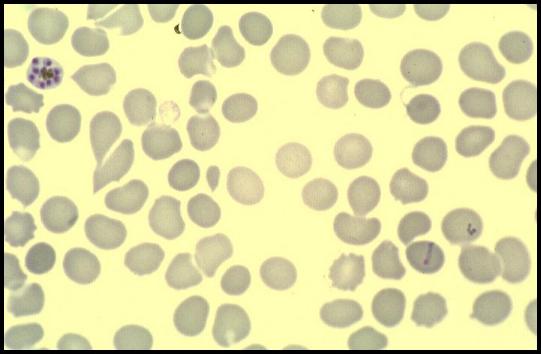
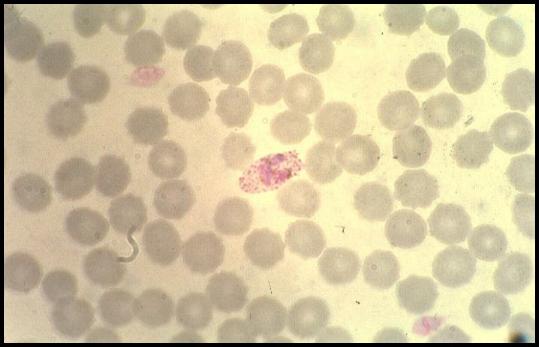

AnkylostomeA
Ascaris lumbricoides oeuf
Brugia malayi microfilaireB
Clonorchis sinensis douve de ChineC
Dicrocoelium dendriticum petite douveD
Diphyllobothrium latum
Echinococcus granulosus 2E
Echinococcus granulosus kyste
Entameoba histolytica histolytica
Entameoba histolytica
Enterobius vermicularis oxyure
Fasciola hepaticaF
Giardia intestinalis forme vegetativeG
Giardia intestinalis kyste avec Bailenger
Leishmania 2L
Leishmania micromastigote
Leishmania promastigote
Loa loa microfilaire
Mansonella perstans microfilaireM
Nodule onchocerquienN
Plasmodium falciparum 4P
Plasmodium falciparum gametocyte
Plasmodium falciparum
Plasmodium malariae
Plasmodium ovale
Plasmodium vivax 2
Plasmodium vivax
Sable hydatique Echinococcus granulosusS
Schistosoma haematobium
Schistosoma mansoni oeuf
Schistosoma mansoni
Strongyloides stercoralis Ankylostome
Taenia saginata proglottis gravideT
Taenia solium proglottis gravide
Taenia solium scolex
Taenia
Toxoplasma kyste
Trichine
Trichinella spiralis
Trichocephale
Trichomonas vaginalis MGG
Trichomonas vaginalis frais
Trypanosoma trypomastigote
Wuchereria bancrofti microfilaireW
HAUT DE PAGE
1Ankylostome

HAUT DE PAGE
2Ascaris lumbricoides oeuf

HAUT DE PAGE
3Brugia malayi microfilaire

HAUT DE PAGE
4Clonorchis sinensis douve de Chine

HAUT DE PAGE
5Dicrocoelium dendriticum petite douve

HAUT DE PAGE
6Diphyllobothrium latum

HAUT DE PAGE
7Echinococcus granulosus 2

HAUT DE PAGE
8Echinococcus granulosus kyste

HAUT DE PAGE
9Entameoba histolytica histolytica

HAUT DE PAGE
10Entameoba histolytica

HAUT DE PAGE
11Enterobius vermicularis oxyure

HAUT DE PAGE
12Fasciola hepatica

HAUT DE PAGE
13Giardia intestinalis forme vegetative

HAUT DE PAGE
14Giardia intestinalis kyste avec Bailenger

HAUT DE PAGE
15Leishmania 2

HAUT DE PAGE
16Leishmania micromastigote

HAUT DE PAGE
17Leishmania promastigote

HAUT DE PAGE
18Loa loa microfilaire

HAUT DE PAGE
19Mansonella perstans microfilaire

HAUT DE PAGE
20Nodule onchocerquien

HAUT DE PAGE
21Plasmodium falciparum 4

HAUT DE PAGE
22Plasmodium falciparum gametocyte

HAUT DE PAGE
23Plasmodium falciparum

HAUT DE PAGE
24Plasmodium malariae
HAUT DE PAGE
25Plasmodium ovale
HAUT DE PAGE
26Plasmodium vivax 2

HAUT DE PAGE
27Plasmodium vivax

HAUT DE PAGE
28Sable hydatique Echinococcus granulosus

HAUT DE PAGE
29Schistosoma haematobium

HAUT DE PAGE
30Schistosoma mansoni oeuf

HAUT DE PAGE
31Schistosoma mansoni

HAUT DE PAGE
32Strongyloides stercoralis Ankylostome

HAUT DE PAGE
33Taenia saginata proglottis gravide

HAUT DE PAGE
34Taenia solium proglottis gravide

HAUT DE PAGE
35Taenia solium scolex

HAUT DE PAGE
36Taenia

HAUT DE PAGE
37Toxoplasma kyste

HAUT DE PAGE
38Trichine

HAUT DE PAGE
39Trichinella spiralis

HAUT DE PAGE
40Trichocephale

HAUT DE PAGE
41Trichomonas vaginalis MGG

HAUT DE PAGE
42Trichomonas vaginalis frais

HAUT DE PAGE
43Trypanosoma trypomastigote

HAUT DE PAGE
44Wuchereria bancrofti microfilaire

HAUT DE PAGE
@